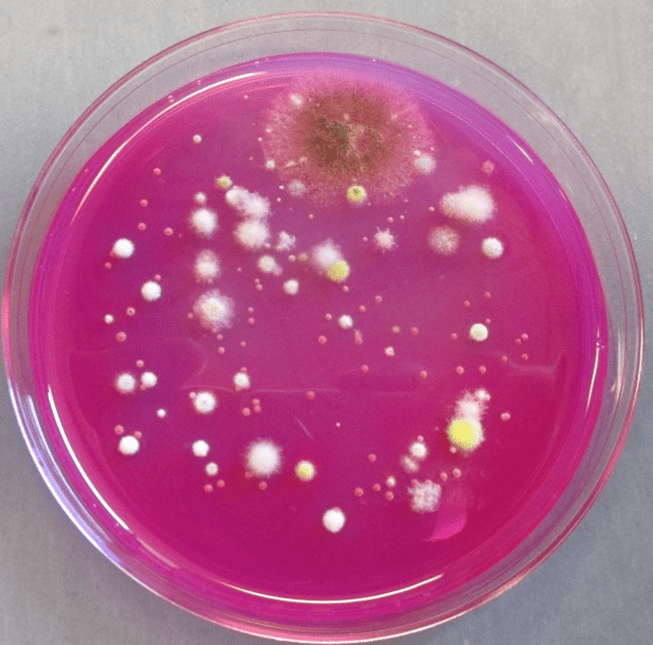
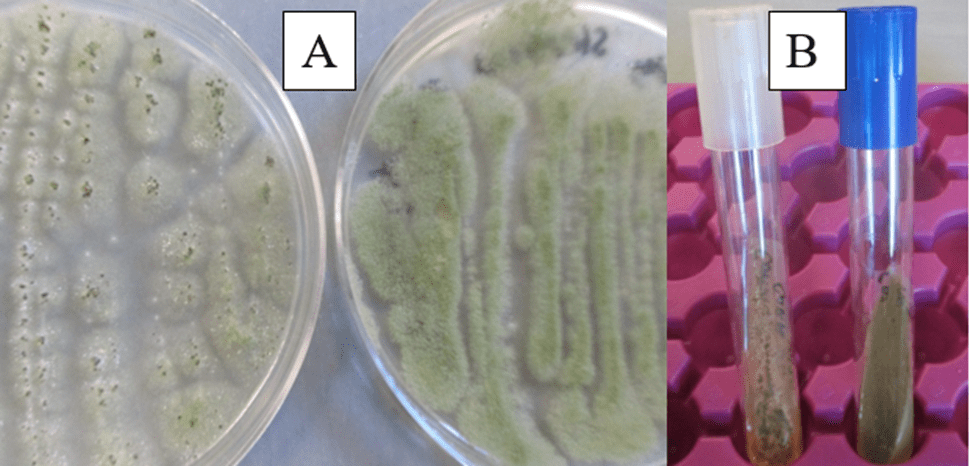

ECONOMICAL PREVENTION OF AFLATOXIN CONTAMINATION WITH A ONE-TIME APPLICATION OF AFLA-GUARD 2024
Thomas Isakeit (PI) and Emi Kimura (Editor)
Funding source: Texas Peanut Producers Board/National Peanut Board
Funding year: 2024
SUMMARY
Aflatoxin contamination, caused by the fungus, Aspergillus flavus, can impact the profitability of peanut production. Afla-Guard, a commercial formulation applied during the growing season as a biological control has been very effective for reducing aflatoxin contamination of corn in Texas. It is also labeled on peanuts, but adoption by peanut growers is not high, presumably because of the added expense and the aflatoxin contamination does not occur every year. Recent studies with corn have shown that the Afla-Guard strain can persist in soil and can be found in corn ears several years after application. The long-term objective of this research is to determine whether one application of Afla-Guard would be persistent enough to prevent aflatoxin contamination on peanuts in subsequent years. In 2023, the initial research on this project started. A peanut field in Comanche County treated with Afla-Guard in August had 78% to 86% atoxigenic (i.e. non-aflatoxin producing strain, such as the Afla-Guard strain) A. flavus in soil sampled October 30. In 2024, this field was planted to cotton and 82% of the A. flavus isolates from this soil were atoxigenic. This contrasts with another field planted to peanuts in Comanche County in 2024 not treated with Afla-Guard. That field had only 18% incidence of atoxigenic A. flavus. These fields provide a baseline for future studies when some of these fields are treated with Afla-Guard and soil populations and peanut contamination are monitored in subsequent years.
PROGRESS IN 2024
Soil was collected from two fields in Comanche County in June. One field in Comanche County (“RS”) was treated by the grower with 15 lb/A Afla-Guard on August 15, 2023 and planted to corn in 2024. The other field was planted to peanuts. To isolate A. flavus from soil, 10 g soil was diluted in 90 ml sterile water and 0.1 ml aliquots were spread onto Petri dishes of modified Rose Bengal agar, which is semi-selective for A. flavus (Figure 1). Colonies of A. flavus were transferred to ½ × potato dextrose agar (PDAS) plates (figure 2A) and pure cultures from plates were inoculated onto PDAS slants in test tubes (figure 2B). After incubation for one week, 20 ml 100% methanol was added to the tubes to extract aflatoxin and, after an overnight incubation, aliquots of the methanol were analyzed for aflatoxin using the Aflatest-FGIS protocol of the Vicam system. This procedure for analyzing isolates for toxigenicity was validated using pure cultures of a toxigenic isolate (NRRL 3357) and the Afla-Guard and AF 36 Prevail atoxigenic strains, as positive and negative controls, respectively. The soil which was treated in 2023 with Afla-Guard had 82% atoxigenic A. flavus (n=11), while a soil planted to peanuts in the same county had 18% atoxigenic A. flavus (n=22). The plan for 2025 is to determine the proportion of atoxigenic isolates in these soils, as well as determine A. flavus colonization of peanuts, when these fields are planted to peanut in the future.
Figure 1. Colony of Aspergillus flavus (arrow) from peanut soil, on Rose Bengal Agar.
Figure 2. A. Aspergillus flavus growing on Petri dishes. B. A. flavus growing on agar slants in test tubes.

Leave a comment